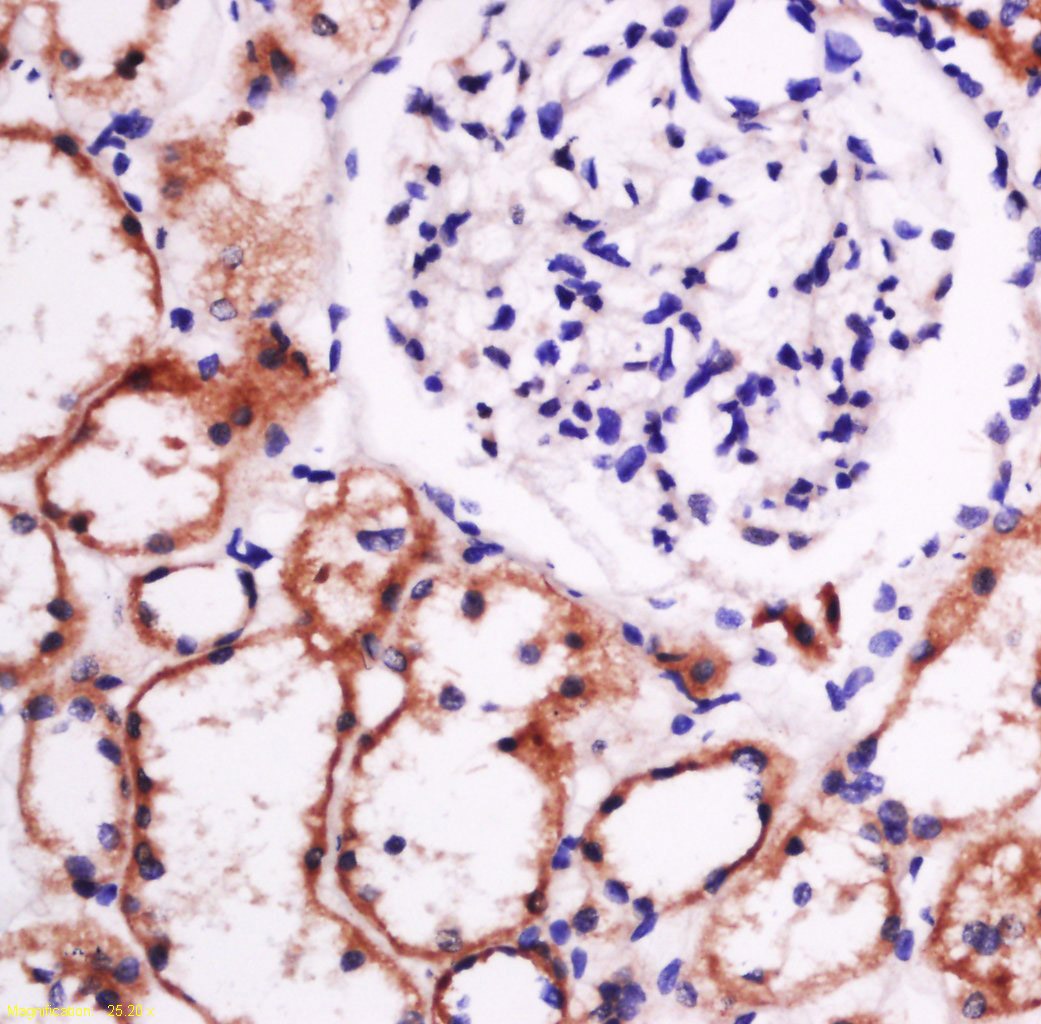
verifiedActivity

您的购物车当前为空
您的购物车当前为空
Anti-Laminin subunit beta-1 Polyclonal Antibody
Synonyms: Laminin-8 subunit beta, Laminin-6 subunit beta, Laminin-2 subunit beta, Laminin-12 subunit beta, Laminin-10 subunit beta, Laminin-1 subunit beta, Laminin subunit beta 1, Laminin B1 chain, LAMB1货号 TMAB-01044 一键复制产品信息
Anti-Laminin subunit beta-1 Polyclonal Antibody 是一种 Rabbit 抗体,靶向 Laminin subunit beta-1。Anti-Laminin subunit beta-1 Polyclonal Antibody 可用于 ELISA,IF,IHC-Fr,IHC-P,WB。
Anti-Laminin subunit beta-1 Polyclonal Antibody
一键复制产品信息货号 TMAB-01044
别名 Laminin-8 subunit beta, Laminin-6 subunit beta, Laminin-2 subunit beta, Laminin-12 subunit beta, Laminin-10 subunit beta, Laminin-1 subunit beta, Laminin subunit beta 1, Laminin B1 chain, LAMB1
Anti-Laminin subunit beta-1 Polyclonal Antibody 是一种 Rabbit 抗体,靶向 Laminin subunit beta-1。Anti-Laminin subunit beta-1 Polyclonal Antibody 可用于 ELISA,IF,IHC-Fr,IHC-P,WB。
Anti-Laminin subunit beta-1 Polyclonal Antibody
| 规格 | 价格 | 库存 | 数量 |
|---|---|---|---|
| 50 μL | ¥ 1,170 | 5日内发货 | |
| 100 μL | ¥ 1,965 | 5日内发货 | |
| 200 μL | ¥ 2,790 | 5日内发货 |
库存状态实时更新,以官网显示为准,现货产品可直接加购物车下单
大包装 & 定制
加入购物车
TargetMol的所有产品仅用作科学研究或药证申报,不能被用于人体,我们不向个人提供产品和服务。请您遵守承诺用途,不得违反法律法规规定用于任何其他用途。
资源下载:产品操作手册
产品介绍
生物活性
抗原信息
化学信息
储存&溶解度
| 产品描述 | Anti-Laminin subunit beta-1 Polyclonal Antibody is a Rabbit antibody targeting Laminin subunit beta-1. Anti-Laminin subunit beta-1 Polyclonal Antibody can be used in ELISA,IF,IHC-Fr,IHC-P,WB. |
| 别名 | Laminin-8 subunit beta, Laminin-6 subunit beta, Laminin-2 subunit beta, Laminin-12 subunit beta, Laminin-10 subunit beta, Laminin-1 subunit beta, Laminin subunit beta 1, Laminin B1 chain, LAMB1 |
| Ig Type | IgG |
| 反应种属 | Human,Mouse,Rat (predicted:Cow) |
| 验证活性 | 1. Tissue/cell: rat intestine tissue; 4% Paraformaldehyde-fixed and paraffin-embedded; Antigen retrieval: citrate buffer (0.01M, pH6.0), Boiling bathing for 15 min; Block endogenous peroxidase by 3% Hydrogen peroxide for 30 min; Blocking buffer (normal goat serum) at 37°C for 20 min; Incubation: Anti-laminin Polyclonal Antibody, Unconjugated (TMAB-01044) 1:500, overnight at 4°C, followed by conjugation to the secondary antibody and DAb staining. 2. Tissue/cell: human kidney tissue; 4% Paraformaldehyde-fixed and paraffin-embedded; Antigen retrieval: citrate buffer (0.01M, pH6.0), Boiling bathing for 15 min; Block endogenous peroxidase by 3% Hydrogen peroxide for 30 min; Blocking buffer (normal goat serum) at 37°C for 20 min; Incubation: Anti-laminin Polyclonal Antibody, Unconjugated (TMAB-01044) 1:500, overnight at 4°C, followed by conjugation to the secondary antibody and DAb staining. 3. Paraformaldehyde-fixed, paraffin embedded (human kidney tissue); Antigen retrieval by boiling in sodium citrate buffer (pH6.0) for 15 min; Block endogenous peroxidase by 3% hydrogen peroxide for 20 min; Blocking buffer (normal goat serum) at 37°C for 30 min; Antibody incubation with (laminin) Polyclonal Antibody, Unconjugated (TMAB-01044) at 1:400 overnight at 4°C, followed by a conjugated secondary for 20 min and DAB staining. 4. Paraformaldehyde-fixed, paraffin embedded (mouse brain); Antigen retrieval by boiling in sodium citrate buffer (pH6.0) for 15 min; Block endogenous peroxidase by 3% hydrogen peroxide for 20 min; Blocking buffer (normal goat serum) at 37°C for 30 min; Antibody incubation with (laminin) Polyclonal Antibody, Unconjugated (TMAB-01044) at 1:400 overnight at 4°C, followed by a conjugated secondary for 20 min and DAB staining. 5. Paraformaldehyde-fixed, paraffin embedded (Mouse brain); Antigen retrieval by boiling in sodium citrate buffer (pH6.0) for 15 min; Block endogenous peroxidase by 3% hydrogen peroxide for 20 min; Blocking buffer (normal goat serum) at 37°C for 30 min; Antibody incubation with (laminin) Polyclonal Antibody, Unconjugated (TMAB-01044) at 1:500 overnight at 4°C, followed by a conjugated secondary for 20 min and DAB staining. 6. Sample: Lane 1: Heart (Mouse) Lysate at 40 μg Lane 2: Skin (Mouse) Lysate at 40 μg Lane 3: Placenta (Mouse) Lysate at 40 μg Lane 4: U2os (Human) Cell Lysate at 30 μg Lane 5: Huvec (Human) Cell Lysate at 30 μg Lane 6: HepG2 (Human) Cell Lysate at 30 μg Lane 7: SH-SY5Y (Human) Cell Lysate at 30 μg Lane 8: A549 (Human) Cell Lysate at 30 μg Lane 9: U251 (Human) Cell Lysate at 30 μg Primary: Anti-laminin (TMAB-01044) at 1/1000 dilution Secondary: IRDye800CW Goat Anti-Rabbit IgG at 1/20000 dilution Predicted band size: 220-240 kDa Observed band size: 240 kDa |
| 应用 | ELISAIFIHC-FrIHC-PWB |
| 推荐剂量 | WB: 1:500-2000; IHC-P: 1:100-500; IHC-Fr: 1:100-500; IF: 1:100-500; ELISA: 1:5000-10000 |
| 抗体种类 | Polyclonal |
| 宿主来源 | Rabbit |
| 亚细胞定位 | reted, extracellular space, extracellular matrix, basement membrane<br>Note: Major component. |
| 组织特异性 | Expressed in tibial nerve and 196 other tissues |
| 构建方式 | Polyclonal Antibody |
| 纯化方式 | Protein A purified |
| 性状 | Liquid |
| 缓冲液 | 0.01M TBS (pH7.4) with 1% BSA, 0.02% Proclin300 and 50% Glycerol. |
| 浓度 | 1 mg/mL |
| 研究背景 | Laminins, a family of extracellular matrix glycoproteins, are the major noncollagenous constituent of basement membranes. They have been implicated in a wide variety of biological processes including cell adhesion, differentiation, migration, signaling, neurite outgrowth and metastasis. Laminins are composed of 3 non identical chains: laminin alpha, beta and gamma (formerly A, B1, and B2, respectively) and they form a cruciform structure consisting of 3 short arms, each formed by a different chain, and a long arm composed of all 3 chains. Each laminin chain is a multidomain protein encoded by a distinct gene. Several isoforms of each chain have been described. Different alpha, beta and gamma chain isomers combine to give rise to different heterotrimeric laminin isoforms which are designated by Arabic numerals in the order of their discovery, i.e. alpha1beta1gamma1 heterotrimer is laminin 1. The biological functions of the different chains and trimer molecules are largely unknown, but some of the chains have been shown to differ with respect to their tissue distribution, presumably reflecting diverse functions in vivo. This gene encodes the beta chain isoform laminin, beta 1. The beta 1 chain has 7 structurally distinct domains which it shares with other beta chain isomers. The C-terminal helical region containing domains I and II are separated by domain alpha, domains III and V contain several EGF-like repeats, and domains IV and VI have a globular conformation. Laminin, beta 1 is expressed in most tissues that produce basement membranes, and is one of the 3 chains constituting laminin 1, the first laminin isolated from Engelbreth-Holm-Swarm (EHS) tumor. A sequence in the beta 1 chain that is involved in cell attachment, chemotaxis, and binding to the laminin receptor was identified and shown to have the capacity to inhibit metastasis. [provided by RefSeq, Aug 2011] |
| 免疫原 | KLH conjugated synthetic peptide: human Laminin subunit beta-1 |
| 抗原种属 | Human |
| 基因名称 | LAMB1 |
| 基因ID | |
| 蛋白名称 | Laminin subunit beta-1 |
| 功能 | Binding to cells via a high affinity receptor, laminin is thought to mediate the attachment, migration and organization of cells into tissues during embryonic development by interacting with other extracellular matrix components. Involved in the organization of the laminar architecture of cerebral cortex. It is probably required for the integrity of the basement membrane/glia limitans that serves as an anchor point for the endfeet of radial glial cells and as a physical barrier to migrating neurons. Radial glial cells play a central role in cerebral cortical development, where they act both as the proliferative unit of the cerebral cortex and a scaffold for neurons migrating toward the pial surface. |
| 分子量 | Theoretical: 198 kDa. Actual: 240 kDa. |
| 储存方式 | Store at -20°C or -80°C for 12 months. Avoid repeated freeze-thaw cycles. |
| 运输方式 | Shipping with blue ice. |
计算器
Related Tags: buy Anti-Laminin subunit beta-1 Polyclonal Antibody | purchase Anti-Laminin subunit beta-1 Polyclonal Antibody | Anti-Laminin subunit beta-1 Polyclonal Antibody cost | order Anti-Laminin subunit beta-1 Polyclonal Antibody | Anti-Laminin subunit beta-1 Polyclonal Antibody molecular weight



 还可以
还可以

 |
|